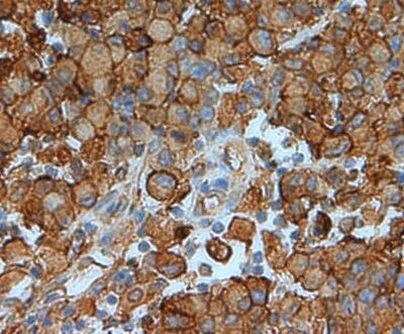
Annexin A2 Antibody in Immunohistochemistry (Paraffin) (IHC (P))

Search
Invitrogen
Annexin A2 Polyclonal Antibody
{{$productOrderCtrl.translations['antibody.pdp.commerceCard.promotion.promotions']}}
{{$productOrderCtrl.translations['antibody.pdp.commerceCard.promotion.viewpromo']}}
{{$productOrderCtrl.translations['antibody.pdp.commerceCard.promotion.promocode']}}: {{promo.promoCode}} {{promo.promoTitle}} {{promo.promoDescription}}. {{$productOrderCtrl.translations['antibody.pdp.commerceCard.promotion.learnmore']}}
图: 1 / 5
Annexin A2 Antibody (PA5-19711) in IHC (P)





Please note: We are reviewing Western blot images included in the antibody testing data in our catalog, including those provided by third parties. Unless expressly labeled or annotated as “raw-unedited”, Western blot images included in the antibody testing data in our catalog may have been edited, optimized or otherwise adjusted for presentation.
产品信息
PA5-19711
种属反应
宿主/亚型
分类
类型
抗原
偶联物
形式
浓度
规格
纯化类型
保存液
内含物
保存条件
运输条件
RRID
产品详细信息
Heat mediated antigen retrieval recommended prior to tissue staining.
This antibody is predicted to react with rat, sheep, cow, dog and pig based on sequence homology.
靶标信息
This gene encodes a member of the annexin family. Members of this calcium-dependent phospholipid-binding protein family play a role in the regulation of cellular growth and in signal transduction pathways. This protein functions as an autocrine factor which heightens osteoclast formation and bone resorption. This gene has three pseudogenes located on chromosomes 4, 9 and 10, respectively. Multiple alternatively spliced transcript variants encoding different isoforms have been found for this gene.
仅用于科研。不用于诊断过程。未经明确授权不得转售。
篇参考文献 (0)
生物信息学
蛋白别名: 33-kDa calcimedin; 33-kDa lymphocyte Ca<2+>- binding protein; 33kDa lymphocyte Ca<2+>- binding protein; 36-kDa calelectrin; Annexin A2; Annexin II; Annexin-2; Calpactin I heavy chain; Calpactin-1 heavy chain; chromobindin 8; Chromobindin-8; Lipocortin II; p36; PAP-IV; Placental anticoagulant protein IV; Protein I
基因别名: ANX2; Anxa2; AW215814; Cal1h
UniProt ID: (Mouse) P07356, (Rat) Q07936
Entrez Gene ID: (Mouse) 12306, (Rat) 56611